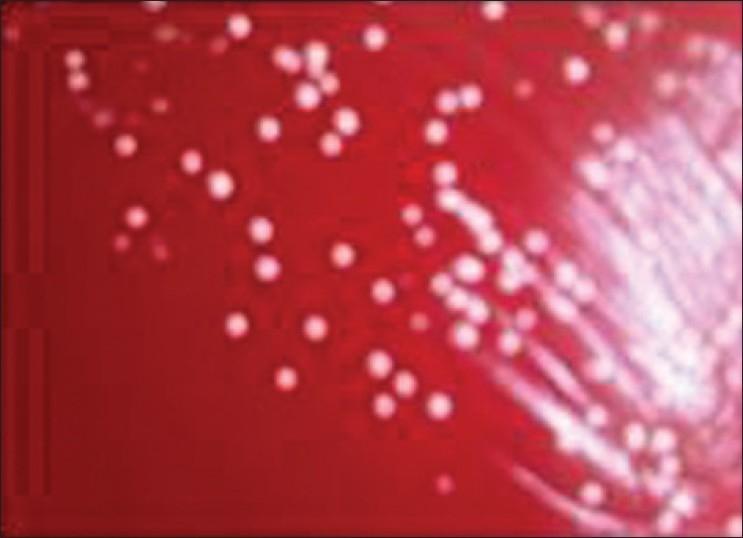
https://cdn.ncbi.nlm.nih.gov/pmc/blobs/78ff/3139288/87f6104f7e34/IJSTD-32-40-g003.jpg

一名艾滋病患者的原发性面部皮肤诺卡菌病及印度皮肤诺卡菌病综述
Primary facial cutaneous nocardiosis in a HIV patient and review of cutaneous nocardiosis in India.
作者信息
Vijay Kumar G S, Mahale Rashmi P, Rajeshwari K G, Rajani R, Shankaregowda Ranjitha
机构信息
Department of Microbiology, JSS Medical College, JSS University, Mysore 570015, Karnataka, India. E-mail:
出版信息
Indian J Sex Transm Dis AIDS. 2011 Jan;32(1):40-3. doi: 10.4103/0253-7184.81254.
Nocardiosis is an acute, subacute or chronic bacterial infection caused by several species of geophilic aerobic bacteria of the genus Nocardia. Cutaneous nocardiosis is an uncommon infectious disease that presents as primary cutaneous infection or as a sequale of disseminated pulmonary nocardiosis. Its rarity and as nocardiosis is not an AIDS defined disease it is often underreported. The global incidence of cutaneous nocardiosis is not exactly known. The frequency of nocardiosis in HIV patients has increased from 0.3 to1.85%. In Immunocompetent persons Primary Cutaneous Nocardiosis is more commonly seen among gardeners and agriculturists. We report a case of extensive primary facial cutaneous nocardiosis due to Nocardia asteroides, in an adult immunocompromised lady who had no pulmonary focus. The lesions were seen as sinus tracts on the zygomatic arch, preauricular and Infraauricular regions. Bacteriological examination of the pus confirmed the presence of N. asteroides. The rarity of the presentation and Cutaneous nocardiosis in India is reviewed.
诺卡菌病是由诺卡菌属的几种嗜土需氧细菌引起的急性、亚急性或慢性细菌感染。皮肤诺卡菌病是一种罕见的传染病,表现为原发性皮肤感染或播散性肺诺卡菌病的后遗症。由于其罕见性且诺卡菌病并非艾滋病定义的疾病,其报告往往不足。全球皮肤诺卡菌病的发病率尚不完全清楚。艾滋病患者中诺卡菌病的发生率已从0.3%增至1.85%。在免疫功能正常的人群中,原发性皮肤诺卡菌病在园艺工人和农业工作者中更为常见。我们报告一例由星形诺卡菌引起的广泛原发性面部皮肤诺卡菌病病例,患者为一名成年免疫功能低下女性,无肺部病灶。病变表现为颧弓、耳前和耳后区域的窦道。脓液的细菌学检查证实存在星形诺卡菌。本文对印度这种罕见的表现及皮肤诺卡菌病进行了综述。